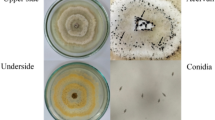

Abstract
The search for alternative methods that are efficient to control phytopathogens is extremely important. For this purpose, the aim of this study is to develop and characterize Neem oil nanoemulsions (Azadirachta indica), as well as evaluate its applicability to fungi Aspergillus flavus and Penicillium citrinum in soybean seeds. Soybean seeds were placed with nanoemulsion containing different Neem oil concentrations (0.5%, 1%, 2%, and 3% w/v) for t1 (600 min) and t2 (30 min). Control samples (positive: infested and untreated; and negative: not infested and treated) were also carried out. Prior to the treatments, the formulated nanoemulsions were characterized by dynamic light dispersion, polydispersity, rheology, and stability test. Subsequently, the soybean seeds were treated with nanoemulsion and then tested for germination and health. The nanoemulsion showed a mean droplet diameter of 59 ± 0.6 nm, and a viscosity of 2.542 ± 0.07 mPa s. The droplet sizes in the nanoemulsion were stable for a period of 20 days and the polydispersity remained around 0.209 ± 0.02. Neem oil had an inhibitory effect on the growth of fungal isolates, being that the highest antifungal activity was observed at the concentration of 3% (w/v) (28 mm inhibition zone for A. flavus and 25 mm for P. citrinum). Neem oil nanoemulsions were efficient against the studied fungi and did not present phytotoxic effects to the seeds. Nanoemulsion is easily accessible, economically viable and, in addition, less toxic than common synthetic pesticides. This study showed that Neem oil nanoemulsions have significant potential applications in agriculture.
Similar content being viewed by others
Explore related subjects
Discover the latest articles, news and stories from top researchers in related subjects.Avoid common mistakes on your manuscript.
Introduction
The exponential growth of the human population brings about the need for sustainable food production, which is one of the challenges for the agricultural sector (Godfray and Garnett 2014; Jordan et al. 2016). Thus, the demand for pesticides and fertilizers plays an important role in maximizing agricultural productivity. However, despite promoting a favorable performance in agriculture, pesticides may be harmful to human health and for non-target organisms, depending on toxicity and degree of contamination (Damalas and Koutroubas 2016). The fungal population presents health risks due to mycotoxin production. Ochratoxin produced by Aspergillus flavus and Penicillium citrinum have nephrotoxic, hepatotoxic, and carcinogenic effects (Geremew et al. 2016; Sorrenti et al. 2013). Therefore, the use of agrochemical products to control these pathogens is an indispensable tool in current agricultural practices. However, the inadequate management of these products is a common problem. Doses above or below the recommended levels result in loss of agrochemical efficiency due to resistant biotypes. Furthermore, excessive use causes considerable waste, increasing production costs of crops and adversely affecting the environment and public health (Oliveira et al. 2014).
Safe and efficient methods of pesticide application are essential for the effective control of these fungi, increasing productivity and decreasing risks to the environment and to humans. Thus, nanotechnology becomes promising as an innovative tool for the safe supply of agrochemicals (Kah and Hofmann 2014; Werdin González et al. 2014). Conceptually, nanoemulsions are colloidal dispersions containing reduced size particles (20–100 nm) dispersed in aqueous medium, depending on the production process (Guttoff et al. 2015). Nanoemulsions are efficient due to increased surface to volume ratio; increase in systemic activity due to smaller particle size and greater mobility; stability and protection against premature degradation; and decreased toxicity due to the elimination of organic solvents from conventionally used pesticides (Athanassiou et al. 2018; Zhao et al. 2017).
Neem oil or Amargozeira (Azadirachta indica) acts as a growth regulator and as an efficient natural pesticide, which has a strong antifungal (Gomes 2013; Shah and Wani 2016), larvicidal and antibacterial action (Chandrasekaran et al. 2015). The biopesticidal applications of Neem oil is associated with its components, especially Azadirachtin, which is a biologically active tetranortriterpenoid (Chaudhary et al. 2017; Kumar et al. 2018). The content of Azadirachtin in Neem oil is 0.068% w/v, obtained by high performance liquid chromatography (HLPC) (Anjali et al. 2012). Osman et al. (2017) investigated the development of nanoemulsions based on Neem and citronella oils against two phytopathogenic fungi Rhizoctonia solani and Sclerotium rolfsii, and potent antifungal activity was observed on the pathogens. However, there is not much information about plant-based oils used as fungicidal agents in agriculture, mainly because of their low solubility in water. Therefore, this study aimed at contributing to better formulation and characterization of Neem oil nanoemulsion products and evaluating its applicability against A. flavus and P. citrinum fungi in soybean seeds.
Material and methods
Chemical reagents
Neem oil was obtained from Lazslo Aromatologia (Brazil) and Tween 20 [polyoxyethylene (20) sorbitan monolaurate (hydrophilic-lipophilic balance, HLB = 16.7)] was obtained from Sigma Aldrich, India. Ultrapure MilliQ water, 18.2 MΩ.cm at 25 °C was used for all analyses. All chemicals were analytical grade.
Microorganisms, storage and standardization of Aspergillus flavus CD 10508 and Penicillium citrinum CD 10564 inocula
The fungal isolates A. flavus CD 10508 and P. citrinum CD 10564 used in this study belong to the collection of cultures from the Mycotoxins and Food Mycology Laboratory of the Department of Food Science of the Federal University of Lavras (Brazil) and were isolated from grapes.
Formulation of the antimicrobial nanoemulsion
The nanoemulsions were prepared according to the experimental plan presented in Table 1, with different Neem oil concentrations (0.5%, 1%, 2%, and 3% w/v). For the evaluation of the antimicrobial efficiency also were used nanoemulsions with the ratios 1:3 and 1:2 (oil/surfactant). Such variations followed Ghotbi et al. (2014) and Sekar et al. (2015), using Neem oil and Tween 20 as the dispersed phase, and water as the continuous phase. The dispersed phase was added dropwise to the continuous phase at room temperature using a magnetic stirrer (RQ1210, Remi Metals Ltd) at 250 rpm for 30 min to create the emulsion. In addition, the coarse emulsion (produced by magnetic stirring) was subjected to high-energy emulsification using a 20 kHz ultrasonic processor with a maximum power of 450 W for 45 min (Branson Digital – Model 450). In order to control the temperature, the sonication processes were performed in cycles, in addition the beakers containing the samples were immersed in an ice bath during the process. Each cycle consisted of 10 min, with 1 min breaks, with amplitude of 50%.
Nanoemulsion characterization
Determination of particle size (DLS) and size distribution (PDI)
The size and distribution of nanoemulsion particles of Neem oil were determined according to Jadhav et al. (2015) using a Zetasizer Nano ZS particle sizer, Malvern Instruments, Malvern United Kingdom. This equipment determines particle size from the relative intensity of fluctuations in the sample dispersion using a laser beam (633 nm) at a 90° angle. Each sample was evaluated in a mean of five replicates. Prior to the measurements being taken, the samples were diluted (×100) using a buffer solution (pH 3.0) to avoid multiplication of dispersion effects and to ensure free Brownian motion of particles. The mean particle diameter (DLS) and polydispersity index (PDI) were calculated from the particle size distribution. All measurements were performed at room temperature.
Viscosity
The nanoemulsion viscosity was determined at 25 °C using a rheometer (HAAKE ReoStress 6000, Thermo Scientific, Karlsruhe, Germany), equipped with a thermostatic bath (HAAKE A10, Thermo Scientific) and a universal temperature control system (HAAKE UTM Controller, Thermo Scientific), Scientific), coupled to a set of concentric cylindrical geometry sensors with a gap of 5.3 mm and a volume of 16.1 mL for all samples. Each sample was subjected to three continuous shear rate ramps (rising, downward, and rising) ranging from 0 to 100 s−1 for 2 min for each curve. The analyses were made in triplicate (Anjali et al. 2012).
Hydrogen ionic potential – pH
The pH values of the nanoemulsion were measured using a Tecnal pH meter calibrated with buffer solutions of 4.0 and 7.0. The determination was made directly on the nanosuspensions at 20 °C. All measurements were performed in triplicate and the results were reported as mean values.
Storage stability of nanoemulsions
The nanoemulsions (20 mL) were conditioned in sterile test tubes and pre-incubated at 20 °C. During designated intervals (0 day, 10 days, and 20 days of production) changes in size and the polydispersity index of the particles were measured using a NanoZS Zetasizer (Malvern Instr., Malvern, UK). A stability study was also performed by centrifugation of the nanoemulsions (Biofuge, Heraeus, Germany) at room temperature at 3500 rpm for 30 min (Shafiq and Shakeel 2010). Macroscopic alterations were observed and reported. The temperature was 20 ± 2 °C.
Fungicidal activity of nanoemulsion
Sensitivity of Aspergillus flavus CD 10508 and Penicillium citrinum CD10564 in neem nanoemulsion in vitro
For the inhibitory effect on filamentous fungi, the disk diffusion test established as standard by the National Committee for Clinical Laboratory Standards (NCCLS) (Barry and Thornsberry 1991; Ostrosky et al. 2008) was used. To reach that result, an inoculum was used at the concentration of 106 spores mL−1, counting in Neubauer chamber. Afterwards, the inoculum was transferred to a Petri dish with malt extract agar medium (MEA) using the surface scattering technique. Filter paper disks with diameter of 6 mm soaked with 10 μL of the nanoemulsions at concentrations of 0.5%, 1%, 2%, and 3% (w/v) were placed in the culture medium. In addition, the effect of the mean particle size on the fungitoxic activity of the emulsion and of the pure oil was also evaluated. The negative control was performed using disks containing 10 μL of DMSO (dimethylsulfoxide) at 10% v/v, which is characterized as cryoprotectant. The fungicide Maxim at 10 μL/5 mL water was used for the positive control. The dishes were incubated in BOD (Biochemical Oxygen Demand) at 25 °C for 72 h. The determination of minimum inhibitory concentration (MIC) was developed, through the classic method of successive dilution. The evaluation was comparative with respect to a reference biological standard (positive control) and the zone or halo of inhibition was measured starting from the circumference of the disk until the growth of microorganisms (Barry and Thornsberry 1991). MIC was defined as the lowest concentration of nanoemulsion, in which the presence of inhibition halo was identified.
Efficacy of neem nanoemulsion against Aspergillus flavus CD 10508 and Penicillium citrinum CD10564 in infected soybean seeds
The soybean seeds, cultivar SYN 1359S IPRO, without chemical treatment were supplied by Syngenta Seeds Ltd. (Uberlândia, MG, Brazil). The seeds were inoculated and germinated according to the methodology adapted from Abd-Elsalam and Khokhlov (2015) and Galletti et al. (2015).
Contamination of seeds by the physiological conditioning method in the presence of fungi
Following the methodology described by Costa et al. (2003), the fungi culture was placed in BDA medium at 25 ± 2 °C to obtain colonies that were later used for the production of a suspension with 106 conidia mL−1. From this suspension, aliquots of 1 mL were spread on BDA solid medium containing mannitol with a water potential of −1.0 Mpa in 15 cm Petri plates. The plates were maintained at 25 °C with a photoperiod of 12 h day−1. After incubating the fungi for seven days, 300 seeds were placed on each plate on a single layer with fungal colony for incubation at 25 °C for 48 h. After the contact period, the seeds were removed and dried for 48 h in laboratory environment to a moisture content of 12%, then stored (10 °C and 50% RH) for later use.
Treatment of infected seeds
After contamination and drying, the experiments were set up in a factorial scheme (4 × 2), in which the seeds were treated with four nanoemulsion concentrations (0.5%; 1%, 2%, and 3% w/v) using 50 mL of each, for two time periods (Time 1–600 min and Time 2–30 min). Four replicate plates (four plates of 15 cm) were used containing 300 soybean seeds for each period and concentration. A total of 72 dishes were used, 36 with seeds treated with A. flavus and P. citrinum, respectively. Untreated and fungi-contaminated seeds were used as positive controls, whereas treated and uncontaminated seeds were used as negative controls.
Germination test in lab
For the germination test, eight replicates of 25 seeds were used. Paper sheets (germitest) were moistened with distilled water up to 2.5 times its dry weight to form rolls. The rolls were kept in a BOD chamber at 25 °C for 7 days, having photoperiods of eight hours a day. Thus, the seeds were uniformly distributed on the sheets to decrease competition and avoid contamination among seeds and seedlings. The results were expressed as percentage of normal seedlings (having all essential structures that are crucial for development).
Health test (modified blotter)
A total of 200 seeds were used for each treatment, divided into eight replicates of 25. These were arranged individually on a layer of filter paper (three overlapped disks) in a solution of 2.4-D (sodium dichlorophenoxyacetate), which is an inhibitor of germination, at the concentration of 10 ppm. Seeds were spaced 1–2 cm apart in 25 cm petri plates. The plates were kept at 20 ± 2 °C for 10 days. Then, the seeds were examined individually using a stereoscopic microscope (resolution of 30-80X) and an optical microscope. Results were expressed as percentage of infected seeds.
Statistical analysis
A completely randomized design with 3, 5, and 8 replications was used to calculate the error and standard deviation, according to the recommendation of each protocol described. The data were submitted to individual analysis of variance (ANOVA) for each fungus. All treatments were compared with the controls by means test (Scheffé, p ≤ 0.05), while the comparison of the means of the germination and blotter tests was done by the Scott Knott test (p ≤ 0.05). The incidence data (%) of fungi in the seeds, obtained through the blotter, were transformed using square root (x + 0.5) transformation method to meet the assumptions of normality and homogeneity of variances for tests. Regression analyses were performed to describe the effects of nanoemulsion concentrations using the SISVAR® software (Ferreira 2014). Finally, the other analyses (droplet size, polydispersity, viscosity, and pH) were performed using the Statistica Analysis Systems software version 8.0 (Statsoft, Inc., Tulsa, USA) and the means were compared using the Tukey test (p ≤ 0.05).
Results and discussion
Nanoemulsion characterization
Determination of particle size (DLS) and size distribution (PDI)
The produced emulsion had diameters above the nanometer scale (397.8 ± 26.9 nm) whereas nanoemulsions had diameters below 60 nm (Table 2). Nanoemulsions particles corresponding to the concentration of Neem oil employed reduced as the concentration of surfactant increased. This benefited the development of small diameters (up to 59 ± 0.61 nm) and reduced turbidity. Emulsion turbidity is a characteristic of concentration and particle size. These nanoemulsions were stable at a ratio of 1:3 due to the surfactant, which restricted the interfacial free energy and provided a mechanical barrier to coalescence (Anjali et al. 2012). Likewise, as reported by Moghimi et al. (2016), the addition of surfactants to nanoemulsion systems caused the interfacial film to condense and stabilize, resulting in small diameters.
The results obtained in this study corroborate the findings of Ghotbi et al. (2014) who reported the formation of NE particles of Neem oil (ratio 1:3) of size in the 30–70 nm range and spherical in shape. As for the size distribution of these particles, the polydispersity was 0.361 ± 0.06 and 0.209 ± 0.02 for nanoemulsion formulations with oil and surfactant ratios of 1:2 and 1:3, respectively. These values differed statistically from those found for the polydispersity of the emulsion (0.528 ± 0.21), which was higher. The polydispersity index is a measure of the particle size distribution, indicating the homogeneity of the nanoemulsion particles, which is an important factor used to evaluate the nanoemulsion stability (Tan et al. 2016). The particle size in the nanoscale range may be due to low polydispersity values (Shinoda and Saito 1969). High polydispersity results in low uniformity of droplet size.
Viscosity
The rheological behavior of the emulsions has been of great interest for practical industrial applications. The viscosity of the selected formulations is shown in Fig. 1. The emulsions (T1 and T6) had a similar viscosity to the ones found on the nanometric scale (T5 and T10). The nanoemulsion formulations (1:3 ratio) had the highest viscosity, 2.542 ± 0.07 mPa s (Table 2). Similarly, the slight increase in particle diameter also provided an increase in the dispersed phase viscosity and, consequently, an increase in flow resistance and restricted rate of droplet disruption (McClements and Rao 2011). The main factors that influence emulsion viscosity are the dispersed phase volume fraction, particle size and charge as well as colloidal interactions (Guerra-Rosas et al. 2016). However, the increase in viscosity may still be due to the increase in the concentration of non-ionic surfactants. According to Florence (1969), this phenomenon occurs because water molecules are trapped in the non-ionic surfactant cross-linking chains. This can be attributed to increased hydration by water molecules around the hydrophilic portion of the surfactants. The same behavior found in this study were reported by other studies (Anjali et al. 2012; Dias et al. 2014).
pH
The increased surfactant and oil concentrations also caused an increase in the nanoemulsion pH values. The nanoemulsion formulations with 1:2 and 1:3 ratios had pH values of 4.80 and 5.65, respectively (Table 2). Similar behaviors were reported by Anjali et al. (2012). The nanoemulsion is more effective at physiological pH (4.5 and 6.0), which is considered another good feature in its potential application as a fungicide (Myc et al. 2002).
Nanoemulsion storage stability
The nanoemulsion stability is distinguished from emulsions due to its greater kinetic stability and less phase separation (Donsì and Ferrari 2016). In this context, the results obtained in this study confirmed that the nanoemulsions withstand the stability tests in a centrifuge, as opposed to the emulsions. No statistical difference was observed among the diameters of nanoemulsion particle for 20 days. They preserved their size, which proves good stability and prevents the occurrence of coalescence (phase separation) (Fig. 2).
Nanoemulsions were physically stable at room temperature with no phase separation while emulsions were not stable. This finding confirmed the fact that nanoemulsions generally have a high kinetic stability (Calligaris et al. 2016). To ensure the long-term kinetic stability of a nanoemulsion, the control of particle size distribution and the selection of a suitable emulsifier are extremely important (McClements 2012). Tween 20 has been a suitable surfactant for the NE formulation; because of its non-ionic nature, it is not affected by pH, besides being considered a non-toxic and biocompatible compound (Chandrasekaran et al. 2015; Ostertag et al. 2012). In this context, the steric effect plays an important role in the nanoemulsion stabilization (Gupta et al. 2016). Nevertheless, Niu et al. (2015) reported that the stability of nanoemulsions can improve as surface charge increases, due to forces produced between the particles against flocculation and coalescence.
Fungicidal activity of the nanoemulsion
Sensitivity of Aspergillus flavus CD 10508 and Penicillium citrinum CD10564 in neem nanoemulsion in vitro
The strength and antifungal activity of nanoemulsions against examined microorganisms were quantitatively assessed by the presence or absence of inhibition zones and MIC values (Fig. 3). Nanoemulsions based on oil and surfactant at a ratio of 1:3 were selected for this study. Nanoemulsion droplet sizes were considered an important parameter for the antifungal study. The results showed that Neem oil has an inhibitory effect on the growth of fungal isolates. The highest antifungal activity was observed at the concentration of 3% (w/v) of Neem oil, T5 (28 mm inhibition zone for A. flavus and 25 mm for P. citrinum). The fungicidal effect at this concentration was equivalent to the positive control used in this study. However, the antifungal action persisted even at lower concentrations (minimum inhibitory concentration, MIC), even in smaller inhibition zones (Fig. 3).
The effect of the mean size of the particles on the fungitoxic activity of the emulsion was also studied. The nanoemulsion ability to inhibit mycelial growth was compared with that of coarse emulsions and pure oil. Thinner and more homogeneous particle size distributions increased the antifungal activity of NEs significantly (p < 0.05) and improved the physical stability of nanoemulsions. This behavior is clearly visible in T5 samples. Coarse emulsions formulated with 3% oil exhibited a 9 mm halo inhibition for A. flavus and absence of inhibition for P. citrinum, whereas nanoemulsions exhibited inhibition with halos larger than 25 mm.
Likewise, growth inhibition for T5 samples showed a significant increase (p ≤ 0.05) in inhibition when using pure oil from 10 mm to 25 mm (Fig. 3). Due to the sub-micron size of the particles, O/W nanoemulsions can penetrate more easily through the fungi membrane when compared to micrometer particles of the emulsion. This leads to an evident increase in antifungal activity by Ribes et al. (2016). The inhibitory effect occurs by the action of the nanoemulsion on fungal hyphae and spore, reducing their viability, especially due to reduced droplet size, which influences their mobility in agar medium. This activity is justified by the fusion of the nanoemulsions with the lipid- containing organisms to destabilize the lipid membrane of the pathogens, resulting in cell lysis and death (Joe et al. 2012).
On one hand, Neem oil has good fungicidal action on a variety of pathogens (Ghosh et al. 2014). On the other hand, little attention has been paid to the antifungal activity of Neem nanoemulsions with different levels of Azadirachtin. However, due to rapid action, small concentrations of nanoemulsions are unlikely to result in the development of resistant strains (Myc et al. 2002). Antifungal properties of Azadirachta indica in inhibition of the production of AFB1 by A. flavus was also established by Sudha et al. (2013). Several studies also reported the significant improvement of the antimicrobial activity when encapsulated in submicron emulsions of different NEs, such as limonene (Donsì et al. 2011) and vegetable oil (Joe et al. 2012), amongst others.
Effects of nanoemulsion on the quality of soybean seeds
Germination test
When comparing treatments T2, T3, T4, and T5 with the positive control, the seeds immersed in the nanoemulsion (T5) for 600 min provided 78% more germination for the A. flavus fungus and 60% more germination for the P. citrinum fungus (Fig. 4). Therefore, the nanoemulsion was very efficient in controlling the effect of these fungi on the germination of soybean seeds. As for the negative control, there were no significant differences (p ≥ 0.05) when compared to other treatments in seed germination, which suggests that the nanoemulsion does not have any phytotoxic effect. A germination test was carried out to determine the initial physiological potential of the seeds, and they presented a mean of 99% germination.
Within each inoculum, the nanoemulsion concentration was not significant for the percentage germination. On the other hand, duration influenced the final stand of normal plants when the inoculation was carried out with the fungus of the genus A. flavus. The duration of 600 min (t1) was favorable to seed germination when compared to 30 min (t2) (Table 3). Seeds infected by A. flavus and in contact with the nanoemulsion for a longer duration (t1) had a significantly higher germination percentage. Thus, it is necessary to consider that the nanoemulsion also provides some advantage to germination, in addition to not presenting phytotoxicity (negative control) to the seeds. Because this is an innovative topic, more research is necessary to better understand why it happened, especially to the physiological quality of the seeds.
Some treatment methods such as high concentrations of chlorine and decontamination by pasteurization impact the germination rate of treated seeds and results in lower yields of germination (Landry et al. 2014). The Neem nanoemulsion was able to inactivate the pathogens without affecting seed germination. Landry et al. (2014), working with carvacrol nanoemulsion on alfalfa seeds also observed a similar behavior in which the nanoemulsion did not affect seed germination. However, Berahmand and Panahi (2012), while using a combination of nanoparticles of SiO2 and TiO2, concluded that nanoparticles could increase the nitrate reductase enzyme in soybean (Glycine max), improve its water absorption capacity, promote its antioxidant system and, in fact, accelerate and increase its germination.
Health evaluation of the seeds contaminated by fungi
Using the blotter test, the concentration and time factors were significant for the isolation (p ≤ 0.05) of both inocula (Table 4). The contamination operation was efficient, since the inoculated seeds (positive control) showed 100% contamination for both fungi. Nanoemulsions based on oil and surfactant were selected in a 1:3 ratio. Nanoemulsion droplet sizes were considered an important parameter for the antifungal study. It has been widely accepted that smaller NPs would have higher surface energy and, therefore, proved to be more toxic to fungal cells (Tang et al. 2012).
Regarding the times, treatments of the contaminated seeds with different concentrations of nanoemulsion for 30 or 600 min produced similar behavior for both fungi. For both inocula, at t1 (30 min) the percentage of infested seeds was lower than in the t2 (600 min). The treatments immersed for 30 min was sufficient to promote a reduction in contamination by 20% on the mean with P. citrinum in relation to the positive control. As for the seeds contaminated with A. flavus, this reduction reached a mean of 50%. A higher time of seed exposure with nanoemulsion favored germination (Fig. 3), but by providing a high moisture content in the seed, it probably benefited the emergence of new fungi, which explains the inefficiency of t1 (Dannemiller et al. 2016). The percentage of fungi that appear in the negative control comes from spores that were already carried by the seed. That means that, if the seeds are not treated, these fungi will proliferate, under favorable conditions, and cause damages to the seeds.
Regarding concentration, a reduction in the percentage of infected seeds was observed in proportion to the increase of the nanoemulsion concentration, for both fungi tested (Fig. 5).
When a microorganism is exposed to external stress at different concentrations of bioactive compounds, there are effects on the genomes that regulate proteins (Abd-Elsalam and Khokhlov 2015). Pandey et al. (2014) also observed that increasing the concentration of botanical oil nanoemulsions in fungal-contaminated pea seeds provided greater elimination of these pathogens. There are several possibilities for the antifungal action of oils, as reported by researchers (Chouhan et al. 2017; Valdés et al. 2017), but the exact mechanism has not been determined yet. For bioactivity, the oil penetrates through the cell wall and the cytoplasmic membrane (Chouhan et al. 2017). These results have allowed us to hypothesize the action of azadirachtin, such as its proportional increase, to inactivate the essential enzymes, to react with the cell membrane or to disturb the genetic material functionality. Nevertheless, the hydrophobic fraction in the phenolic oils is dissolved in the hydrophobic domain of the cytoplasmic membrane between the acyl lipid chains. This disintegrates the outer membrane and increases the cytoplasm membrane permeability to the adenosine triphosphate of fungal cells, eventually leading to its death (Pandey et al. 2014). In addition, the susceptibility of the microorganisms to the oils has been shown to be dependent on the treatment pH. A lower pH not only increases stress for cells, but also increases the transfer of fungal membrane oils, increasing their observed efficacy (Landry et al. 2014). The Neem nanoemulsion treatment presented in this study has a pH of 4.8 (Table 2) which utilizes the synergistic effects of both pH stress and an increase in the affinity of azadirachtin to the fungal membrane. Lower pH values not only increase cell stress, but also increases the transfer of oils from fungal membranes and increases efficacy (Landry et al. 2014).
Conclusion
The nanoemulsion formulation containing Neem oil, Tween 20, and deionized water was successfully optimized by the high-energy method. A drop size of less than 60 nm and stability over a long period was obtained. The Neem oil nanoemulsion with the smallest particle size was found to be more effective in the antifungal control of Aspergillus flavus and Penicillium citrinum. The reduced size and uniform spread of these fine particles increased antifungal efficacy both in in vitro tests and contaminated seeds. In this study, the Neem oil nanoemulsions were efficient in the control of fungi and did not present phytotoxic effects to the seeds. Moreover, they may also favor the increase of contaminated seeds germination. Nanoemulsions are easily accessible, economically viable and less toxic than the usual synthetic pesticides. This study shows that Neem oil nanoemulsions may contain considerable potential applications in agriculture as they can selectively inhibit harmful fungi in plant fields and release essential elements for plant growth.
References
Abd-Elsalam, K. A., & Khokhlov, A. R. (2015). Eugenol oil nanoemulsion: Antifungal activity against Fusarium oxysporum f. sp. vasinfectum and phytotoxicity on cottonseeds. Applied Nanoscience, 5, 255–265.
Anjali, C., Sharma, Y., Mukherjee, A., & Chandrasekaran, N. (2012). Neem oil (Azadirachta indica) nanoemulsion-a potent larvicidal agent against Culex quinquefasciatus. Pest Management Science, 68, 158–163.
Athanassiou, C. G., Kavallieratos, N. G., Benelli, G., Losic, D., Usha Rani, P., & Desneux, N. (2018). Nanoparticles for pest control: Current status and future perspectives. Journal of Pest Science, 91, 1–15.
Barry, A. L., & Thornsberry, C. (1991). Susceptibility tests: Diffusion test procedures. In A. Balows, W. J. Hauser, K. L. Hermann, H. D. Isenberg, & H. J. Shamody (Eds.), Manual of clinical microbiology (5th ed., pp. 1117–1125). Washington, DC: American Society for Microbiology.
Berahmand, A. A., & Panahi, A. G. (2012). Effects silver nanoparticles and magnetic field on growth of fodder maize (Zea mays L.). Biological Trace Element Research, 149, 419–424.
Calligaris, S., Plazzotta, S., Bot, F., Grasselli, S., Malchiodi, A., & Anese, M. (2016). Nanoemulsion preparation by combining high pressure homogenization and high power ultrasound at low energy densities. Food Research International, 83, 25–30.
Chandrasekaran, N., Jayakumar, J., Makwana, P., Kumar, S., Mukherjee, A., & Sundaramoorthy, R. (2015). Antibacterial activity of neem nanoemulsion and its toxicity assessment on human lymphocytes in vitro. International Journal of Nanomedicine, 10, 77–86.
Chaudhary, S., Kanwar, R. K., Sehgal, A., Cahill, D. M., Barrow, C. J., Sehgal, R., & Kanwar, J. R. (2017). Progress on Azadirachta indica based biopesticides in replacing synthetic toxic pesticides. Frontiers in Plant Science, 8, 1–13.
Chouhan, S., Sharma, K., & Guleria, S. (2017). Antimicrobial activity of some essential oils: Present status and future perspectives. Medicines, 4, E58.
Costa, C. M. C., Cavalcante, U. M. T., Lima, M. R., Jr., & Maia, L. C. (2003). Inoculum density of arbuscular mycorrhizal fungi needed to promote growth of Hancornia speciosa Gomes seedlings. Fruits, 58, 247–254.
Damalas, C. A., & Koutroubas, S. D. (2016). Farmers’ exposure to pesticides: Toxicity types and ways of prevention. Toxics, 4, 1–10.
Dannemiller, K. C., Weschler, C. J., & Peccia, J. (2016). Fungal and bacterial growth in floor dust at elevated relative humidity levels. Indoor Air, 27, 354–363.
Dias, D.d. O., Colombo, M., Kelmann, R. G., Kaiser, S., Lucca, L. G., Teixeira, H. F., Limberger, R. P., Veiga, V. F., & Koester, L. S. (2014). Optimization of copaiba oil-based nanoemulsions obtained by different preparation methods. Industrial Crops and Products, 59, 154–162.
Donsì, F., & Ferrari, G. (2016). Essential oil nanoemulsions as antimicrobial agents in food. Journal of Biotechnology, 233, 106–120.
Donsì, F., Annunziata, M., Sessa, M., & Ferrari, G. (2011). Nanoencapsulation of essential oils to enhance their antimicrobial activity in foods. LWT - Food Science and Technology, 44, 1908–1914.
Ferreira, D. F. (2014). Sisvar: A guide for its bootstrap procedures in multiple comparisons. Ciência e Agrotecnologia, 38, 109–112.
Florence, A. (1969). Micellar size, shape, and hydration of nonionic surfactants. Journal of Colloid and Interface Science, 31, 580–583.
Galletti, S., Fornasier, F., Cianchetta, S., & Lazzeri, L. (2015). Soil incorporation of brassica materials and seed treatment with Trichoderma harzianum: Effects on melon growth and soil microbial activity. Industrial Crops and Products, 75, 73–78.
Geremew, T., Abate, D., Landschoot, S., Haesaert, G., & Audenaert, K. (2016). Occurrence of toxigenic fungi and ochratoxin a in Ethiopian coffee for local consumption. Food Control, 69, 65–73.
Ghosh, V., Mukherjee, A., & Chandrasekaran, N. (2014). Optimization of process parameters to formulate Nanoemulsion by spontaneous emulsification: Evaluation of Larvicidal activity against Culex quinquefasciatus Larva. BioNanoScience, 4, 157–165.
Ghotbi, R. S., Khatibzadeh, M., & Kordbacheh, S. (2014). Preparation of neem seed oil nanoemulsion. Nanotechnology: Fundamentals and applications. https://avestia.com/ICNFA2014_Proceedings/papers/150.pdf. Accessed 20 November 2018.
Godfray, H. C. J., & Garnett, T. (2014). Food security and sustainable intensification. Philosophical transactions of the Royal Society B: Biological Sciences, 369, 20120273.
Gomes, S. (2013). Neem (Azadirachta indica) and its potential for safeguarding health of animals and humans: A review. Journal of Agricultural Science, 14, 110–123.
Guerra-Rosas, M. I., Morales-Castro, J., Ochoa-Martínez, L. A., Salvia-Trujillo, L., & Martín-Belloso, O. (2016). Long-term stability of food-grade nanoemulsions from high methoxyl pectin containing essential oils. Food Hydrocolloids, 52, 438–446.
Gupta, A., Eral, H. B., Hatton, T. A., & Doyle, P. S. (2016). Nanoemulsions: Formation, properties and applications. Royal Society of Chemistry, 12, 2826–2841.
Guttoff, M., Saberi, A. H., & McClements, D. J. (2015). Formation of vitamin D nanoemulsion-based delivery systems by spontaneous emulsification : Factors affecting particle size and stability. Food Chemistry, 171, 117–122.
Jadhav, A. J., Holkar, C. R., Karekar, S. E., Pinjari, D. V., & Pandit, A. B. (2015). Ultrasound assisted manufacturing of paraffin wax nanoemulsions: Process optimization. Ultrasonics Sonochemistry, 23, 201–207.
Joe, M. M., Bradeeba, K., Parthasarathi, R., Sivakumaar, P. K., Chauhan, P. S., Tipayno, S., Benson, A., & Sa, T. (2012). Development of surfactin based nanoemulsion formulation from selected cooking oils: Evaluation for antimicrobial activity against selected food associated microorganisms. Journal of the Taiwan Institute of Chemical Engineers, 43, 172–180.
Jordan, N. R., Dorn, K., Runck, B., Ewing, P., Williams, A., Anderson, K. A., Felice, L., Haralson, K., Goplen, J., Altendorf, K., Fernandez, A., Phippen, W., Sedbrook, J., Marks, M., Wolf, K., Wyse, D., & Johnson, G. (2016). Sustainable commercialization of new crops for the agricultural bioeconomy. Elementa: Science of the Anthropocene, 4, 81–91.
Kah, M., & Hofmann, T. (2014). Nanopesticide research: Current trends and future priorities. Environment International, 63, 224–235.
Kumar, R., Mehta, S., & Pathak, S. R. (2018). Bioactive constituents of neem. In A. Tewari & S. Tiwari (Eds.), Synthesis of medicinal agents from plants (pp. 75–103). Amsterdam: Elsevier.
Landry, K. S., Chang, Y., McClements, D. J., & McLandsborough, L. (2014). Effectiveness of a novel spontaneous carvacrol nanoemulsion against Salmonella enterica Enteritidis and Escherichia coli O157: H7 on contaminated mung bean and alfalfa seeds. International Journal of Food Microbiology, 187, 15–21.
McClements, D. J. (2012). Nanoemulsions versus microemulsions : Terminology, differences, and similarities. Soft Matter, 8, 1719–1729.
McClements, D. J., & Rao, J. (2011). Food-grade Nanoemulsions: Formulation, fabrication, properties, performance, biological fate, and potential toxicity. Critical Reviews in Food Science and Nutrition, 51, 285–330.
Moghimi, R., Aliahmadi, A., & Rafati, H. (2016). Ultrasonic nanoemulsification of food grade trans-cinnamaldehyde : 1,8-cineol and investigation of the mechanism of antibacterial activity. Ultrasonics Sonochemistry, 35, 415–421.
Myc, A., Vanhecke, T., Landers, J. J., Hamouda, T., & Baker, J. R. (2002). The fungicidal activity of novel nanoemulsion (X8W 60 PC) against clinically important yeast and filamentous fungi. Mycopathologia, 144, 195–201.
Niu, F., Zhou, J., Niu, D., Wang, C., Liu, Y., Su, Y., & Yang, Y. (2015). Synergistic effects of ovalbumin/gum arabic complexes on the stability of emulsions exposed to environmental stress. Food Hydrocolloids, 47, 14–20.
Oliveira, J. L., Campos, E. V. R., Bakshi, M., Abhilash, P. C., & Fraceto, L. F. (2014). Application of nanotechnology for the encapsulation of botanical insecticides for sustainable agriculture: Prospects and promises. Biotechnology Advances, 32, 1550–1561.
Osman, E., Ali, M., Shakil, N. A., Rana, V. S., Sarkar, D. J., Majumder, S., Kaushik, P., Singh, B. B., & Kumar, J. (2017). Antifungal activity of nano emulsions of neem and citronella oils against phytopathogenic fungi, Rhizoctonia solani and Sclerotium rolfsii. Industrial Crops and Products, 108, 379–387.
Ostertag, F., Weiss, J., & McClements, D. J. (2012). Low-energy formation of edible nanoemulsions: Factors influencing droplet size produced by emulsion phase inversion. Journal of Colloid and Interface Science, 388, 95–102.
Ostrosky, E. A., Mizumoto, M. K., Lima, M. E. L., Kanek, T. M., Nishikawa, S. O., & Freitas, B. R. (2008). Métodos para avaliação da atividade antimicrobiana e determinação da Concentração Mínima Inibitória (CMI) de plantas medicinais. Revista Brasileira de Farmacognosia, 18, 301–307.
Pandey, A. K., Singh, P., Palni, U. T., & Tripathi, N. N. (2014). In vivo evaluation of two essential oil based botanical formulations (EOBBFs) for the use against stored product pathogens and pests, Aspergillus species and Callosobruchus species (Coleoptera: Bruchidae). Journal of Stored Products Research, 59, 285–291.
Ribes, S., Fuentes, A., Talens, P., Barat, J. M., Ferrari, G., & Donsì, F. (2016). Influence of emulsifier type on the antifungal activity of cinnamon leaf, lemon and bergamot oil nanoemulsions against Aspergillus niger. Food Control, 73, 784–795.
Sekar, G., Sivakumar, A., Mukherjee, A., & Chandrasekaran, N. (2015). Probing the interaction of neem oil based nanoemulsion with bovine and human serum albumins using multiple spectroscopic techniques. Journal of Molecular Liquids, 212, 283–290.
Shafiq, S., & Shakeel, F. (2010). Stability and self-nanoemulsification efficiency of ramipril nanoemulsion containing labrasol and plurol oleique. Clinical Research and Regulatory Affairs, 27, 7–12.
Shah, M. A., & Wani, S. H. (2016). Nanotechnology and insecticidal formulations. Journal of Food Bioengineering and Nanoprocessing, 1, 285–310.
Shinoda, K., & Saito, H. (1969). The stability of O/W type emulsions as functions of temperature and the HLB of emulsifiers: The emulsification by PIT-method. Journal of Colloid and Interface Science, 30, 258–263.
Sorrenti, M., Di Giacomo, C., Acquaviva, R., Barbagallo, I., Bognanno, M., & Galvano, F. (2013). Toxicity of Ochratoxin a and its modulation by antioxidants: A review. Toxins, 5, 1742–1766.
Sudha, S., Naik, M. K., & Ajithkumar, K. (2013). An integrated approach for the reduction of aflatoxin contamination in chilli (Capsicum annuum L.). Journal of Food Science and Technology, 50, 159–164.
Tan, S. F., Masoumi, H. R. F., Karjiban, R. A., Stanslas, J., Kirby, B. P., Basri, M., & Basri, H. B. (2016). Ultrasonic emulsification of parenteral valproic acid-loaded nanoemulsion with response surface methodology and evaluation of its stability. Ultrasonics Sonochemistry, 29, 299–308.
Tang, Y. J., Wu, S. G., Huang, L., Head, J., Chen, D., & Kong, I. C. (2012). Phytotoxicity of metal oxide nanoparticles is related to both dissolved metals ions and adsorption of particles on seed surfaces. Journal of Petroleum & Environmental Biotechnology, 3, 2–6.
Valdés, A., Ramos, M., Beltrán, A., Jiménez, A., & Garrigós, M. C. (2017). State of the art of antimicrobial edible coatings for food packaging applications. Coatings, 7, 56.
Werdin González, J. O., Gutiérrez, M. M., Ferrero, A. A., & Fernández Band, B. (2014). Essential oils nanoformulations for stored-product pest control - characterization and biological properties. Chemosphere, 100, 130–138.
Zhao, X., Cui, H., Wang, Y., Sun, C., Cui, B., & Zeng, Z. (2017). Development strategies and prospects of Nano-based smart pesticide formulation. Journal of Agricultural and Food Chemistry, 66, 6504–6512.
Acknowledgments
This study was financed in part by the Coordenação de Aperfeiçoamento de Pessoal de Nível Superior – Brasil (CAPES) - Finance Code 001. The authors wish to thank the financial support the CNPq and FAPEMIG, technical support and supply of equipment the Embrapa Instrumentation.
Author information
Authors and Affiliations
Corresponding author
Ethics declarations
Conflict of interest
There are no conflicts of interest on the part of the authors in this work.
Ethics approval and consent to participate
There is no research involving human and / or animal participants.
Rights and permissions
About this article
Cite this article
de Castro e Silva, P., Pereira, L.A.S., de Rezende, É.M. et al. Production and efficacy of neem nanoemulsion in the control of Aspergillus flavus and Penicillium citrinum in soybean seeds. Eur J Plant Pathol 155, 1105–1116 (2019). https://doi.org/10.1007/s10658-019-01838-4
Accepted:
Published:
Issue Date:
DOI: https://doi.org/10.1007/s10658-019-01838-4